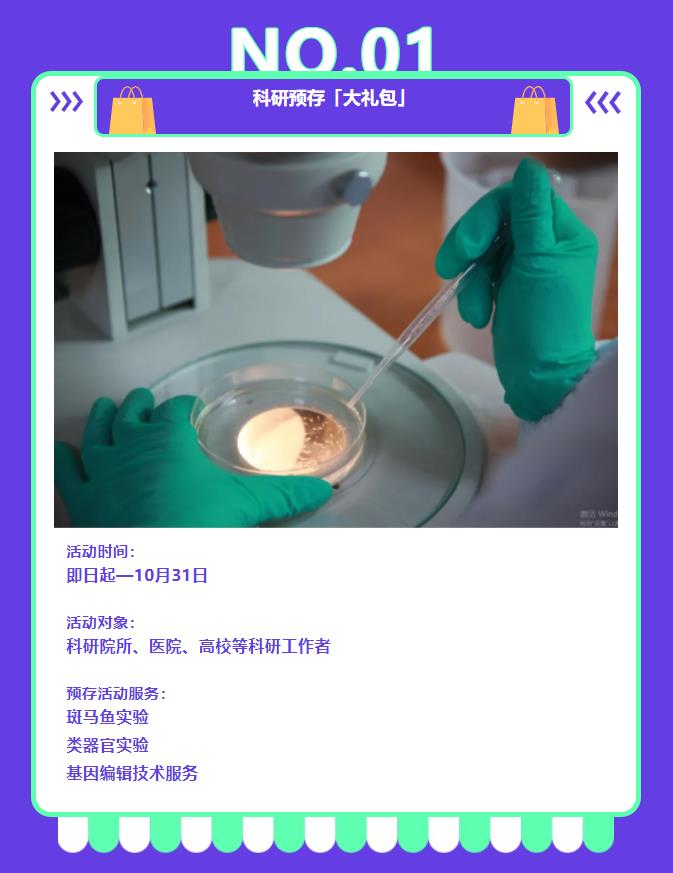
新闻图片1

13 年
手机商铺
入驻年限:13 年
成经理
浙江 杭州市 滨江区
实验室仪器 / 设备、抗体、试剂、细胞库 / 细胞培养、论文服务、技术服务
生产厂商 科研机构
公司新闻/正文
83 人阅读发布时间:2025-09-11 14:34
一键解锁您的福利——开学大礼包
2025/9.10~10.31
金秋九月,开学季遇上感恩的敬意,为回馈大家一直以来的支持与信任,环特生物推出专属「开学大礼包」,科研预存福利全新升级,诚意加倍,快乐加倍,斑马鱼、类器官、基因编辑服务,多项技术,多重惊喜限时放送,助您科研更省一筹,更胜一筹!
即日起—10月31日,满减抵扣更划算,老荐新皆有礼,预存即享好礼,奖励叠加不停,让新学期快乐加倍,科研之路高光开启!
一起点亮您的“研”值时刻,速来解锁!!
科研好物 开学季轻松get

老用户推荐新用户,新客户消费满5000元,老用户即可获得200元京东卡一张,并可0元享超大试用装的常规类器官培养试剂盒(100ml大容量,比20ml左右小样更有诚意);
被推荐新用户,消费满20000元,新老双方都可获得500元京东卡一张,并可享受0元享超大试用装福利。
备注说明:
1.活动权益仅限在活动有效期内的下单客户;
2.本活动只针对促销期间的订单,不与其它促销活动及折扣同享;
3.取消订单将视为放弃参加此次促销活动;
4.0元超大试用装赠送的试剂盒仅限于胃癌、结直肠癌、小鼠小肠、小鼠结肠、人小肠、人结肠、人胃上皮类器官培养试剂盒;
5.本活动最终解释权归环特生物所有。